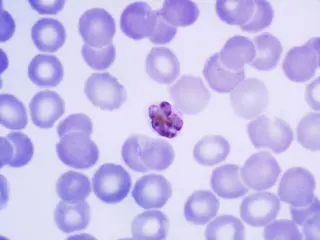

Unas bacterias podrían neutralizar gases de efecto invernadero
Sandra Arteaga
Investigadores de la Universidad de Florida han hallado una bacteria en las aguas profundas que podría neutralizar los gases contaminantes de efecto invernadero.